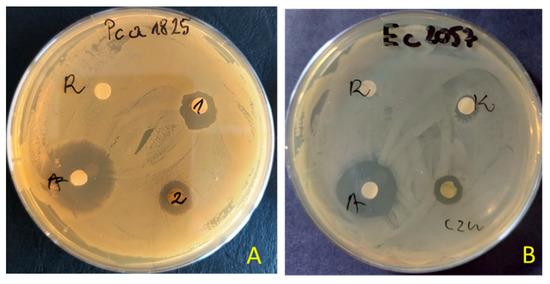

Abstract
This study evaluated in vitro antibacterial, antifungal, anticancer and antioxidant activities of methanolic leaf and root extracts from Solanum nigrum L. and determined its chemical composition. The chemical profile of S. nigrum L. extract was tested using liquid chromatography coupled with tandem mass spectrometry (LC-MS/MS). Disc diffusion and microdilution assays were used for the antibacterial activities. Antifungal activity was measured using the poisoned food technique. In vitro activity on the cell culture model was assessed by MTT assay, viability measurement and by determination of cellular ROS by DCFDA assay. The minimal inhibitory concentrations for extracts from aerial parts ranged from 125 to 500 μg/mL for gram-positive cocci and Pectobacterium strains. The growth inhibition coefficient ranged from 17–56%, depending on the dosage. The antifungal effect of S. nigrum extracts on the tested filamentous fungi depended on the dose. An inhibitory effect of 50–56% on fungi was observed against Alternaria alternata and Chaetomium globosum. The study showed a reduction in cellular vitality of THP1, A549, MCF7 and HeLa cancer lines using both extracts. In addition, there was a decrease in the number of viable cells in cultures incubated with the extract of aerial parts and a reduction in oxygen radicals in the cells. The obtained results indicate the possibility of using S. nigrum extracts from the aerial part as antimicrobial factors. Both extracts show chemopreventive properties by inhibiting the growth of cancer cells and reducing the level of free radicals. Both extracts show chemopreventive properties by inhibiting cancer cell growth and lowering free radical levels. The broad biological activity of the studied extracts can be used in agriculture, veterinary usages and medicine.
1. Introduction
The search for new and effective antibacterial and antifungal agents is one of the key challenges of modern medicine and agriculture due to the ever-growing phenomenon of resistance to microorganisms [1,2,3,4]. Natural substances enjoy unflagging popularity in the era of enormous technological progress despite the widespread presence of synthetic care preparations and plant protection products. The world of plants and microorganisms is an inexhaustible source of various natural ingredients. The combination of bioactive compounds with commonly used antibiotics or pesticides may reduce the risk of acquiring resistance by microorganisms and may also allow the dose of chemotherapeutic and plant protection products to be reduced without reducing their effectiveness. Due to their antimicrobial activity, plant extracts and essential oils have become the basis of many applications,= including pharmaceuticals, the preservation of raw and processed food, alternative medicine and natural therapies [5,6]. Moreover, plants produce numerous secondary metabolites with antimicrobial, antioxidant and antitumor activity [7,8,9]; flavonoids show a strong chemopreventive effect [10].
Chemoprevention is the use of chemicals or biological drugs/substances to prevent or delay the development of a specific disease, especially tumors. Earlier scientific research has suggested that using plant-derived compounds in the diet reduces cancer risk. Today, chemoprevention is widely used to reduce the risk of developing colorectal cancer. Therefore, food-derived phytochemicals and their derivatives are a rich source of compounds with anticancer activity. Among these, flavonoids represent a considerable group. Due to their differences in structure, they are further categorized into anthocyanins, flavones, flavonols, flavanones, flavanols, isoflavones or chalcones and occur in various forms: as glycoside derivatives or as free aglycones. These compounds are an important part of the human diet as they are naturally present in fruits, vegetables, cereal grains, tea and wines [9]. In addition, flavonoids exhibit various biological functions including its antioxidant, anti-inflammatory and anti-angiogenic properties [10] which are important for their chemopreventive activity [11].
In addition, epidemiological studies suggest that higher dietary consumption of flavonoids affects life expectancy [12,13], partly because they exhibit anticancer effects [14,15]. Therefore, scientists have been interested in the influence of substances of natural origin, including flavonoids, on various types of neoplastic cells including human lung cancer, breast cancer and cervical cancer [16,17,18]. Secondary metabolites such as essential oils constituents, phenolic compounds, saponosides and alkaloids remain the object of much in vivo as well as in vitro research [19,20,21,22].
Solanum nigrum L., belonging to the family Solanaceae Juss., is commonly known as black nightshade or simply blackberry nightshade. This plant is native to the region of Eurasia and was later introduced in the Americas, Australasia and South Africa. Black nightshade is a common agricultural weed throughout the world [22,23]. Amongst compounds identified in Solanum nigrum L. are alkaloids (solanine, soladulcine, solasodine, chaconine), steroid saponins, resins and essential oils with constituents, among others, including dillapiol, α-cadinol, p-cymene, α-phellandrene, β-pinene and dyes: brown, green and blue. Nevertheless, black nightshade is considered a poisonous plant despite all those beneficial features due to its high solanine content [24,25,26].
Moreover, Nightshade consumption may lead to respiratory, circulatory and gastrointestinal disorders (diarrhea, nausea or vomiting). However, in traditional medicine, black nightshade was still used to treat wounds, ulcers and diarrhea and remedy toothache and nosebleeds. In addition, some people apply black nightshade directly to the skin for a skin condition called psoriasis, hemorrhoids and deep skin infections (abscesses). Unfortunately, there isn’t enough information to know how black nightshade might work as medicine [27]. Furthermore, there is only limited information in the scientific literature on the effects of S. nigrum L. extracts on a broad spectrum of pathogens, including human, animal and plant pathogens as well as cell cultures and cancer cells [28,29,30,31,32].
This study aimed to investigate the chemical composition of S. nigrum L. aerial parts and root extracts to evaluate their biological properties (e.g., antibacterial, antifungal, chemopreventative and/or antioxidative). The selection of lines used was dictated by the composition of the extracts, the possibilities of their use in chemoprevention and earlier studies by other authors. It should be noted that the plant extracts studied differ from those studied by other authors. Therefore, the results presented in this paper should be considered as the beginning of research on compounds obtained from S. nigrum L.
2. Results
2.1. Chemical Profiling
The total flavonoid compound concentration for S. nigrum roots and aerial parts was determined as 12.49 ± 0.17 mg QE/g dry extract and 15.73 ± 0.22 mg QE/g dry extract, respectively. Regarding the detailed analysis based on research by Wu et al. (2013) [32], twenty-four compounds that belonged to flavonoids (Table 1), steroidal glycosides, steroidal glycoalkaloids or steroidal alkaloids groups (Table 2) were searched for extracts, and nineteen of them were found in at least one sample. Among flavonoids, delphinidin-3-O-(6″-O-α-rhamnopyranosyl)-β-glucopyranoside, isoquercitrin, naringenin and pelargonidin-3-O-(6″-O-α-rhamnopyranosyl)-β-glucopyranoside were found, both in aerial parts and root extract; while among steroidal glycosides, steroidal glycoalkaloids or steroidal alkaloids solamargine, solanine, solasodine, solasonine and tomatine were found in both extracts (source chromatograms are given as Supplementary Files).

Table 1.
S. nigrum methanolic extracts flavonoids content (%).

Table 2.
S. nigrum methanolic extracts steroidal glycosides, steroidal glycoalkaloids and steroidal alkaloids’ profile.
2.2. Microbial Assay
The preliminary antimicrobial values from testing extracts were achieved using agar disc diffusion methods for tested extracts of S. nigrum (Table 3). The extracts (100 μg/disc) of S. nigrum showed varying degrees of inhibitory effects. The zone of inhibition produced by the reference antibiotics (tetracycline or amphotericin B) was between 22.0 and 42.0 mm, 2–4 fold larger than that produced by the extract (0.0–11.5.0 mm). The maximum zone of inhibition was observed against plant pathogens of Pectobacterium strains (zone inhibition ~7–11.0 mm). The extract from aerial parts showed better antibacterial activity than from roots. The inhibitory effect was observed against nine bacteria, and against five in the case of the root extracts. Both extracts showed no inhibitory activity against B. cereus, P. aeruginosa, S. marcescens and Candida spp. An example of the zone of inhibition in the presence of aerial parts or root extracts of S. nigrum is shown in Figure 1.

Table 3.
Antimicrobial activity of aerial parts and root extracts of S. nigrum using disc diffusion method (zone of inhibition in mm).
Figure 1.
Examples of zones of growth inhibition of P. atrosepticum 1825 (A) and E. coli 2057 (B) by extracts of S. nigrum aerial parts (1 = czn) and roots (2 = K) (R—solvent 10% DMSO, A—antibiotics tetracycline—30 μg/disc).
Table 4 showed the antibacterial activity of methanolic extracts from S. nigrum aerial parts and roots tested by serial dilution method determining MIC/MCB. Microbes used in this study are associated with various forms of infections in people, animals and plants. In our research, the extract of black nightshade showed antibacterial effectiveness at variable degrees, with MIC90 values varying from 125 to <500 μg/mL. The extracts from aerial parts showed better antimicrobial activity against different bacterial strains than roots. Generally, extracts from aerial parts exhibit MIC ranging from 125 to 250 µg/mL, while extracts from roots have an MIC of usually 500 µg/mL or above. The lowest minimum inhibitory concentration was found against a plant pathogen from genus P. carotovora strain 1815 and 1822 (MIC = 125 μg/mL) and gram-positive cocci (MIC = 250 μg/mL). However, the bactericidal effect was observed at a 2-fold concentration (MBC = 250 μg/mL or MBC = 500 μg/mL, respectively). The extracts from the aerial parts also inhibited the growth of endospore-forming bacilli and E. coli but at a concentration of MIC = 500 μg/mL. The extract from roots did not exhibit activity against S. aureus, Bacillus spp., E. coli, P. aeruginosa and C. albicans at the tested concentrations.

Table 4.
The MIC90 and MBC values (µg/mL) of Solanum nigrum methanol extracts against pathogenic bacterial strains.
Table 5 and Table 6 show antifungal activity of the tested extracts of S. nigrum L. Most of the tested filamentous fungi did not react uniformly to the presence of black nightshade extracts. Aspergillus niger, A. versicolor, Epicocum nigrum and Fusarium oxysporum, depending on the dose and the extract, showed a slight acceleration or slowing down of the colony growth rate (Table 4). The species most stimulated by the extract from the aerial parts of black nightshade at a dose of 500 µg/mL was A. flavus. The coefficient of colonies’ growth inhibition for this combination was −29 mm (growth stimulation). Root extract in the same dose did not strongly stimulate growth (H = −9 mm), and in lower doses, it inhibited its growth. Penicillium notatum was significantly inhibited by black nightshade root extract. Depending on the dosage, the growth inhibition coefficient ranged from 17–36% (Table 6). The same coefficient with the use of aerial parts extract did not exceed 9%. Bipolaris sorokiniana, after applying black nightshade root extract at a dose of 500 µg/mL, was inhibited at the level of 43%. The same dose of the extracts from the aerial parts inhibited the fungus by 20%. The highest antifungal activity of S. nigrum extracts was recorded in the case of Alternaria alternata and Chaetomium globosum. For both fungi, the growth inhibition coefficient value rose with the extract dosage increase, reaching 55 and 56, respectively, in the highest dose of 500 µg/mL.

Table 5.
Colonies linear growth rate Index (in mm) of filamentous fungi on media with the addition extracts from of Solanum nigrum.

Table 6.
The coefficient of colonies growth inhibition or stimulation (%) of filamentous fungi with the addition of extracts from Solanum nigrum.
2.3. Cell Culture
The effect on cell culture viability during the MTT assay in the biological activity assays is shown in Figure 2. In parallel, the evaluation of the number of viable cells (Figure 3) in the automated counter was also carried out to determine whether the effect observed in the MTT assay is related to cell growth inhibition or the cytotoxicity of the tested extracts. The tested extracts differ in their impact on cell cultures. In the case of normal cells and human fibroblasts (Figure 2a), an increase of 33% in the number of fibroblasts was observed when an extract from aerial parts was used at a concentration of 250 μg/mL. A greater increase in cell number is also seen at concentrations of 100 and 500 μg/mL. The increase in viability in the MTT test suggests a faster proliferation of fibroblasts and a possible pro-regenerative effect of the tested extract. No cell growth-promoting effect is seen for the other concentrations nor the root extract. The root extract has little inhibitory effect on cell vitality. For fibroblast cells, no impact on the number of viable cells can be seen in Figure 3.


Figure 2.
MTT test results. NHDF (a), THP1 (b), A549 (c) MCF-7 (d), HeLa (e) results after 24 h incubation with the tested plant extracts at 5 concentrations. Results are averages of 5 independent experiments ± SEM. Results are presented as the ratio of the value obtained in the test to the control culture. Differences between results for tested plant extracts compared to control and between extracts (* p < 0.05).

Figure 3.
The percentage of living cells for the cell lines compared to the control (at a concentration of 500 μg/mL). Statistical significance of differences between the results for the tested compounds compared to the control for each line separately (* p < 0.05).
The other cell lines tested were cancer cell lines. The monocytic line THP1 is used as a model for the effect of compounds on cells involved in inflammation. We observed a decrease in cell viability in the MTT assay for this line. A greater effect was observed with the root extract. It already exerted an inhibitory influence on cells from the lowest concentration tested, and this effect was dependent on the concentration of the extract. In the case of the extract from aerial parts, the inhibitory effect was weaker and visible only at a concentration of 100 μg/mL. An impact on the number of living cells was found for the extract from above-ground parts (15% compared to the control).
For the other lung, breast and cervical cancer lines tested, the activity of both extracts was similar, and both showed an inhibitory effect on cancer cells. For the MCF7 line, the extract from the aerial parts shows less impact on vitality, especially at the highest concentration tested. The activity of both extracts is concentration-dependent. The reduction in vitality ranged, depending on the line, from 43% (A549) to 59% (MCF7) (Figure 2). A decrease in the number of viable cells was also observed for the three cell lines (Figure 3). This was clearly evident after incubation with extracts isolated from the aerial parts of the plant. In the case of the root extract, no such effect was observed. The results indicate that the observed effect in the MTT assay is due to a reduction in cell growth. Compared to the control, the decrease in cell viability is small, ranging from 9.4 (HeLa) to 11.9 (MCF7).
The effect of the tested extracts on the level of oxygen radicals ROS in fibroblast cultures was also evaluated during the cell model studies (Figure 4). First, tests were performed on cells incubated with the tested extracts. Then, tests were performed on cells not subjected to oxidative stress and incubated with 100 μM H2O2 solution. In both cases, the effect of the tested extracts was observed, consisting of a reduction of ROS in the cells. The observed effect was concentration-dependent and occurred in cultures not subjected to oxidative stress and incubated with H2O2. In both variants, a greater impact was found for the root extracts. In resting incubation, a difference was observed for the 500 µg/mL concentration and for incubation with H2O2 at 250 and 500 µg/mL concentrations. The decrease in ROS was 41% and 49% at maximum concentrations for the root extract, respectively.

Figure 4.
ROS levels in NHDF cells incubated in the presence of the tested extracts (at concentrations of 25–500 μg/mL;): untreated (a) and treated with H2O2 (100 μM, 30 min) (b). Control value for (a) 79.7 RFU ± 5.50; (b) 2551.0 RFU ± 94.32. Results are presented as RFU (relative fluorescent units) of fluorescence level. Statistical significance of the differences between the results for the tested compounds compared to the control and between the tested extracts (* p < 0.05).
The effect of incubation on radical oxygen levels is also evident in the figure showing NHDF line cells pre-incubated with extracts and H2O2. The fluorescence intensity is directly proportional to oxidative stress in the cells. In Figure 5a, cells not incubated with extracts are shown, and the strong green fluorescence of the DCFDA indicator is visible. In Figure 5b,c the fluorescence is weaker; the cells shown show low fluorescence. This indicates a lower level of ROS in the cells. In Figure 5c, more cells are visible than in the control. This effect was also observed in the MTT assay when there was an increase in cell viability.

Figure 5.
Determination of cellular ROS by DCFDA assay. Representative fluorescence images were taken by an EVOS FL fluorescence microscope, ex. 482 em. 524. Microphotographs show fluorescence of 2′,7′-dichlorodihydrofluorescein (DCFH-DA) in NHDF cells. (a) control; (b) incubation with root extract, (c) incubation with extract from aerial parts. 10× objective magnification.
3. Discussion
This study determined the concentrations of compounds in the methanol extracts of S. nigrum in the above-ground parts and the roots. In the first study examined, the total flavonoid content determined by Aryal et al. (2019) [33] was 16.42 mg QE/g of dry extract, while in our study, we determined total flavonoid content to be 15.73 mg QE/g of dry extract. Regarding the root portion of S. nigrum, there are no reliable sources in the scientific literature reporting flavonoid content. Only for plants belonging to the same family, such as wolfberry (S. xanthocarpum) (Schrad. And Wendl), the total content of flavonoids in the root was 15.83 mg QE/g of the dry extract [34]. Moreover, our extracted compounds from S. nigrum, both from the ground and the root parts, partially coincide with the composition published by Wu et al. (2013) [35]. This study also identified naringenin, naringenin-7-O-glucoside, kaempferol-3-O-rutinoside-7-O-glucoside, cyanidin-3-O-(6″)-O-α-rhamnopyranosyl)-β-glucopyranoside, del-finidin-3-O-(6″-O-α-rhamnopyranosyl)-β-glucopyranoside, pelargonide-in-3-O-(6″-O-α-rhamnopyranosyl)-β-glucopyranoside or tomatin compared to studies by Wu et al. (2013) [35]. All those compounds may be found in Solanum plants, including S. nigrum [35,36,37]. Different plant chemotypes can cause these differences, which are well documented in the scientific literature on plant secondary metabolites [34]. Moreover, Wu et al. (2013) [35] do not state whether the roots were also used for extraction in their studies of plants, which may also be the reason for the noted differences.
Studies have shown the highest antimicrobial activity of compounds such as isoquercetin and naringenin and its derivatives: rutin, demysin, solamargine, solanidine, solanine, solasodine, solasin and tomatin, the activity of which has been repeatedly mentioned in numerous scientific reports [36,37,38,39,40,41,42]. All these compounds or groups to which they belong can be found in the concise review by Chauhan et al., (2012) [37] on the therapeutic role of S. nigrum, especially in terms of antiviral, antimicrobial, anti-inflammatory and antitumor activity. In addition, some plant protective actions, such as cardioprotective or hepatoprotective, have also been described. A similar but more comprehensive review report by Atanu et al. (2011) [36] also draws attention to the mentioned actions. Additionally, it points to the important role of solanine in terms of antitumor activity in S. nigrum extracts. Nevertheless, solanine and its related compounds, with a small amount of protein, are more often associated with toxic effects [39]. Despite its anti-cancer effects, the presence of solanine can cause headaches, colic, skin warming, nausea and some physical symptoms such as weakness or depression. Moreover, by focusing on the antimicrobial activity of S. nigrum, Gadoh Abbas et al. (2009) [43] highlighted an important role of solasodine in the control of wound-related microbes such as S. aureus, S. epidermidis, E. coli and P. aeruginosa. Additionally, Chowdhury et al. (2008) [44] indicated that some steroid compounds are responsible for the activity of other plants from the Solanaceae family; S. villosum can regulate the reproduction of S. aegypti, which may have a significant impact on the spread of dengue fever, dengue hemorrhagic fever and dengue shock syndrome.
Earlier reports highlighted that S. nigrum extracts exhibited biological activity against Gram-negative and Gram-positive bacteria as well as fungi (e.g., [37,45,46,47,48,49]). The antimicrobial activity of S. nigrum extracts was tested in the concentration range from 25 μg/mL to 200 mg/mL and was found to depend on the qualitative and quantitative composition of the test extracts [7,37,45,46,47,48,49]. In our research, the antimicrobial activity of the extracts of S. nigrum from aerial parts and roots was tested by the disc diffusion method and serial dilution method to determine MIC/MCB. Our results showed different degrees of inhibition of growth against the pathogens tested. The methanolic extracts showed a broad antibacterial spectrum against the tested bacteria with the diameter of the zone of inhibition varying from 4 to 11.5 mm (13–41% against the control). However, the minimum inhibitory concentration (MIC90) ranged from 125 to 500 μg/mL. However, the extract from aerial parts showed a stronger antimicrobial effect than the extract from roots. Plant pathogens (Pectobacterium spp. and Erwinia spp.) and gram-positive cocci were the most sensitive to the tested extracts. The observed antibacterial activity is probably related to the contents of plants, including Solanaceae, including alkaloids, glycoalkaloids, tannins and terpenoids, which can penetrate the bacterial wall and/or cell membrane and have bacteriostatic or bactericidal effects by penetrating deep into the cell [45].
The tested extracts showed activity against cells of tumor lines by inhibiting cell growth. There are few reports in the literature on the activity of extracts obtained from S. nigrum. Ongoing research [30] showed activity with significant cytotoxicity in human endometrial cancer cells by activating autophagy and cell death. An aqueous leaf extract was used in the study; however, its composition is missing. The following paper on in vitro activity evaluates the antioxidant activity of methanolic and aqueous extracts. The extracts were partially characterized in terms of composition. SN leaf extracts could reduce oxidative stress in primary cultures of rat astroglial cells. In addition, the extracts showed antioxidant properties and neuroprotective effects. According to the authors, natural phenolic antioxidants in functional foods prevent neurodegenerative diseases. Another study investigated the extracts’ antiproliferative activity against cells of leukemia lines. Furthermore, in this study, the activity of the extracts was confirmed [28].
In the study of antitumor activity, methanol and chloroform extracts from S. nigrum leaves and stems were also used [30]. The authors assessed the activity of the extracts in in vitro studies on the PC-3 human prostate cancer cell line and the HeLa cervical cancer cell line. Additionally, tests were carried out on normal cells. All extracts at a 100 µg/mL concentration showed anti-tumor activity and were not toxic to normal cells. This study confirmed S. nigrum in treating cancer in traditional medicine in Sudan [30].
S. nigrum is used in traditional medicine as an antiviral, anti-inflammatory and hepatoprotective agent [28,30,50,51,52,53]. The cited literature data confirm the results obtained. The tested extracts show activity consisting in inhibiting cell growth. It is visible in MTT test results and approved by a direct cytotoxicity test (Figure 1). The results of the MTT test confirm the antiproliferative activity of the tested compounds, confirming the literature data. The compounds themselves show low cytotoxicity. The obtained results indicate new possibilities of anticancer application of extracts in the prevention of lung cancer or breast cancer using lines A549 and MCF7. Conducted research will be expanded in the future to evaluate the mechanism of extracts’ examination on cells. Due to the high content of polyphenols, we planned to investigate the effects of extracts on the level of oxygen and nitrogen free radicals, and thus, on lipid peroxidation and potential DNA strand damage or on the possibility of intercalation with DNA. It is also planned to determine whether the tested extracts also affect pro-apoptotic proteins, e.g., p53 and whether there is a resulting increase in the number of cells in a state of apoptosis or only inhibition of cell division. Moreover, we are currently investigating the effect of adding these extracts simultaneously with doxorubicin, which is commonly used in therapeutic regimens for colorectal cancer. As is well known, the risk of multidrug resistance in colorectal cancer is high, so it is important to look for substances that can prevent the release of cytostatic from cancer cells. The results obtained in this study are promising and allow for a deeper understanding of the actions of the obtained mixture of compounds in extracts from the upper part of the plant and the roots and of their fractions separately to determine the potential synergistic effects. Pelargonidin is particularly noted when assessing the polyphenols’ composition in the tested extracts. This compound is present in high amounts in both studied extracts, especially in the extract from the root. This compound shows strong anticancer effects through apoptosis and induction of cell cycle arrest. The high contents of this potent compound may explain the chemopreventive activity of the studied extracts [54,55].
Extracts from S. nigrum are used in traditional medicine as anti-inflammatory agents. This may be related to their effect on the proliferation of inflammatory cells, such as monocytes. Therefore, the THP1 line is a good model to study the anti-inflammatory activity of the compounds. The results obtained showed growth inhibition of this cell line as well.
The results obtained (Figure 4) also confirm the above antioxidant properties. The tested extracts can have a protective effect on cells by reducing the level of oxygen free radicals. Importantly, their impact was observed in cells not subjected to oxidative stress and those incubated with H2O2. Due to the higher polyphenols content, the extract from aerial parts shows better activity.
The extract from aboveground parts also stimulated fibroblast proliferation. The effect was not large, but it was nevertheless intensive. The enhancement of the growth of normal cells may explain the pro-regenerative impact of the extracts used in traditional medicine.
4. Materials and Methods
4.1. Plant Material and Extract Preparation
Plant material for the preparation of bioactive methanol fractions of the Solanum nigrum L. was collected in June 2019 from a maize field in Malin, Poland (51.220534, 17.059176). Complete shoots and roots of plants obtained from the field were cut into small pieces and then subjected to drying in a drying cabinet at 25–30 °C for 72 h. The relative humidity of the milled material was <10%. Dried aerial parts and roots were ground in a grinder (IKA POL M20 Werke) and extracted with absolute methanol (ratio: 1: -5, w/v). Further, the mixture was shaken for 60 min on a rotary shaker (125 rpm). Finally, the crude extracts were filtered and dried with a rotary evaporator (VWR IKA). The dry extracts were weighed and stored at 4 °C until tested.
4.2. Chemical Analysis
4.2.1. Total Flavonoid Content
Total flavonoid compounds concentration in S. nigrum aerial parts and root extracts were determined according to the method described by Aryal et al. (2019) [33]. Briefly, 1 mL of plant extract (20–200 µg/mL), aluminum chloride solution (10% w/v), 0.2 mL potassium acetate (1 M) and 5.6 mL distilled water were added together, and the mixture was prepared for 30 min. After that, the samples were subjected to absorbance read with Cintra 303 spectrometer (GBC Scientific Equipment Ltd., Dandenong, Australia) at 415 nm. The results were expressed as mg of quercetin equivalents (QE).
4.2.2. LC-MS/MS Analysis
Methanol extracts (5 mg/mL) from the aerial parts and roots of S. nigrum were diluted 1000 and 100 times with Chromasolv grade methanol (Sigma Aldrich, Steinheim, Germany). Then 100 µg of luteolin (Sigma-Aldrich, Steinheim, Germany) was added as an internal standard. The obtained dilutions were then filtered through Phenex-RC syringe filters (Phenomenex, Torrance, CA, USA) and subjected to chemical profiling according to the procedure developed by Wu et al. (2013) [35], which allowed for a comprehensive study of the chemistry of Solanum species. Compounds belonging to the flavonoid, steroid or glycosides, glycoalkaloids or alkaloids were selected for screening as they have the greatest potential for antimicrobial or antioxidant activity. The screening was performed on an LCMS-8045 instrument (Shimadzu, Kyoto, Japan) equipped with a Kinetex 2.6u C18 100A 100 × 3.0 mm column with a 3 mm ULTRA shell (Phenomenex, Torrance, CA, USA).
The mobile phase used for the chromatographic separation consisted of 0.1% aqueous formic acid (A) and methanol (B). A solvent gradient was applied from 10% to 80% B in 0–3 min, 80% B in 3–15 min and 80 to 10% B in 15–20 min. The flow rate and injection volumes were 0.3 mL/min and 10 µL, respectively. The column temperature was set to 40 °C.
Mass spectrometry was performed by electrospray ionization (ESI) under the following conditions: Q3 SIM (m/z details are given in Table 1 in positive mode); nitrogen for nebulization (flow 3 L/min) and desolvation (temperature 526 °C); both heating as well as a drying gas flow of 10 L/min; interface; DL and heating block temperatures of 300, 250 and 400 °C, respectively.
Flavonoid quantification was based on normalization of the peak area based on the peak area of the internal standard. The analyses were carried out in triplicate.
4.3. Antimicrobial Activities
4.3.1. Test Microorganisms
The obtained methanolic extracts of S. nigrum were tested against a wide range of microorganisms, including Gram-positive cocci: Micrococcus luteus PCM 1944 (ATCC 10240), Staphylococcus aureus PCM 2054 (ATCC 25923), Staphylococcus pseudintermedius PCM 2741, Streptococcus agalactiae PCM 2683, Streptococcus canis KW-Sac1, Bacillus subtilis PCM 1949 (ATCC 6633); Gram-positive endospore-forming rods: Bacillus cereus PCM 2019 (ATCC 11778); Gram-negative rods: Escherichia coli PCM 2057 (ATCC 25922), Pseudomonas aeruginosa PCM 2058, Serratia marcescens PCM 501; as well as plant pathogens: Pectobacterium carotovora sbp. carotovora IOR strains 1815 and 1822, Pectobacterium atrosepticum IOR 1825, Erwinia chrysantemi IOR 1452; yeasts: Candida albicans ATCC 10231, Candida parapsilosis KW-Cp1; and filamentous fungi: Alternaria alternata, Aspergillus flavus, A. niger, A. versicolor, Cheatomium globosum, Cladosporium herbarum, Epicoccum nigrum, Penicillium notatum, Bipolaris sorokiniana, Fusarium oksysporum, Trichoderma harzianum sbp. aggressivum KW-Tha1. These strains came from the following collections: PCM—Polish Collection of Microorganisms (Institute of Immunology and Experimental Therapy, Polish Academy of Sciences, Wroclaw, Poland), IOR—Culture Collection of Plant Pathogens at Institute of Plant Protection (Poznan, Poland), KW—own collection (Division of Biogeochemistry and Environmental Microbiology, University of Environmental and Life Sciences, Wroclaw, Poland). Filamentous fungi were from the Division of Phytopathology and Mycology (the University of Environmental and Life Sciences, Wroclaw, Poland). Cultures of bacteria were maintained on TSA (Tryptic Soy Agar, Sigma-Aldrich, St. Louis, MO, USA), and yeast and filamentous fungi were maintained on PDA (Potato Dextrose Agar, Biocrop, Warsaw, Poland). Strains were stored on slants at 4 °C.
4.3.2. Agar Disc Diffusion Assay
The disc diffusion method measured the antibacterial activity of methanolic extracts [56]. First, 100 μL of bacterial suspension containing 1.5 × 108 CFU/mL or yeast suspension containing 1.5 × 106 CFU/mL was spread on Mueller Hinton agar (MHA, Sigma-Aldrich, St. Louis, MO, USA) or Sabouraud dextrose agar medium (SDA, BTL, Łódź, Poland), respectively. The turbidity of the tested strains was standardized to 0.5 McFarland (spectrophotometer VIS-723G, Rayleigh, Beijing). Then, paper discs (Whatman no. 1, England, 6 mm diameter) were placed on the agar surface and impregnated with 30 μL of stock solutions of 100 µg/mL. For a negative control and a solvent, 10% DMSO was used. In addition, filter discs impregnated with 30 µg/mL tetracycline (Sigma-Aldrich) or amphotericin B (Gibco, Life Technologies, USA) were used as a positive reference control for bacteria and fungi, respectively. The plates, after remaining at 4 °C for 2 h, were incubated at 37 °C (24 h) for bacterial strains and at 30 °C (48 h) for yeasts. Antimicrobial activity was evaluated by measuring the diameters of inhibition zones in millimeters. The experiment was done in triplicate, and mean values are presented (Table 2).
4.3.3. Determination of Minimum Inhibitory Concentration, Minimum Bactericidal Concentration and Half Inhibitory Concentration
The minimum inhibitory concentrations (MICs) were determined by a serial dilution method [57] in 96-well plates (Tissue Culture Plates VWR European). The bacterial species were cultured in Mueller-Hinton agar (MHA, Sigma-Aldrich, St. Louis, MO, USA) at 36 °C (Pectobacterium spp. at 28 °C) for 20 h. After cultivation, bacterial suspensions were made in Mueller-Hinton broth (MHB, Sigma-Aldrich, St. Louis, MO, USA), and their turbidity was standardized to 0.5 McFarland (spectrophotometer VIS-723G, Rayleigh, Beijing). The bacterial inoculum’s final optical density (OD) was ~5 × 105 CFU/mL. The dry methanolic extracts were dissolved in 10% DMSO (dimethylsulfoxide) and were prepared in a 500 to 62.5 μg/mL concentration. As a positive control, a solvent (10% DMSO) was used as negative control along with tetracycline (30 µg/mL, Sigma-Aldrich). The plates were then incubated at 36 °C (Pectobacterium spp. at 28 °C), and the bacterial growth was observed after 20 h by measuring the optical density (OD) with a microplate photometer (Thermo Scientific, Waltham, MA, USA, MultiscanGO; λ = 570 nm). The experiments were done in three series at four repetitions. The minimum inhibitory concentration (MIC90) was the lowest concentration of assayed extracts that caused 90% growth inhibition as compared to the positive control. It was determined by calculating the percentage inhibition of bacterial growth by the following formula [(Equation (1)]:
where:
ODpc is the mean value of the measured optical density of the positive control.
ODs is the mean value of the measured optical density of the extracts of the test sample.
Minimum bactericidal concentration (MBC) was defined as the lowest extract concentration that killed 99% of microorganisms. To determine MBC, cultures were taken from each well without visible growth and inoculated on MHA.
4.4. Antifungal Activity
Antifungal activity was measured using the poisoned food technique [58]. First, methanolic extracts dissolved in 10%DMSO were added to the liquified PDA medium (cooled to 50 °C) to obtain 50, 100, 250 and 500 µg/mL concentrations. Then the medium was poured into Petri dishes. After solidifying the medium with the addition of extracts, injections were done with discs (8 mm diameter) cut out from the edge of an actively growing one-week-old colony and placed in the center of test Petri dishes. In the case of Aspergillus and Penicillium, 20 µL of spore suspensions were used as inoculum. The concentrations of the spore suspensions were determined in a hemacytometer and adjusted to 2.5 × 106 spores per mL. Linear growth of the mycelium was measured for nine days, every 24 h. Incubation was carried out at 24 °C. The control contained diluents (DMSO) at a dose of 50, 100, 250 and 500 µg/mL. All tests were done in triplicate, in two series.
The obtained results were expressed in the linear growth index and the colony growth inhibition or stimulation coefficients. The linear growth index is calculated using the following Formula (2) [59]:
where:
T—linear growth index, A—average measurements of colony diameter (mm), D—duration of the experiment (days), b1–bx—the diameter increase of the colony since the last measurement (mm), d1–dx—the number of days since the previous measurement.
Coefficient of inhibition (H) or stimulation (S) of the radial growth of fungi—H (%) calculated by the modified Abbott Formula (3) [59]:
where:
H—coefficient of radial growth inhibition of the fungus, K0—the diameter of the colonies on the control Petri dish, F—the diameter of the colonies on the Petri dish containing certain levels of plant extract.
4.5. Evaluation of Biological Activity on Cell Cultures
4.5.1. Cell Lines and Conditions
Five human cell lines were used in this study, which provides a good model for in vitro assessment of cytotoxicity and anti-tumor activity. In addition, studies were also performed on a monocytic line often used to study inflammation.
Normal human dermal fibroblasts (NHDF) were purchased from Lonza (Verviers, Belgium) and were cultured in Dulbecco’s modified Eagle medium (DMEM) without phenol red (Biological Industries, Beit-Haemek, Israel). The remaining cells were purchased from the European Collection of Authenticated Cell Cultures (ECACC). Cancer cells A549 (lung cancer), MCF7 (breast cancer) and HeLa (cervical cancer) were cultured in Minimum Essential Medium (MEM) (Biological Industries, Beit-Haemek, Israel). In addition, a monocyte cell line (THP-1) derived from acute monocytic leukemia was cultured in suspension in RPMI-1640 medium Biological Industries (Beit-Haemek Israel). All cell lines were cultured in a 95% humidified incubator at 37 °C and 5% CO2 in a complete culture medium. In addition, EMEM, RPMI-1640 and DMEM media without phenol red were supplemented with penicillin (10,000 U/mL), streptomycin (10 mg/mL), L-glutamine (200 mM) and 10% fetal bovine serum (FBS) (Biological Industries, Beit-Haemek Israel).
4.5.2. Cell Culture Tests
Each cell line was cultured from thaw for 2 weeks before testing. The cells were detached with trypsin/EDTA solution to start the assay. Medium containing 10% FBS was used to neutralize the effect of the trypsin/EDTA solution. The cells were then centrifuged (200× g), stained with 0.4% trypan blue solution, counted, and their viability was assessed in a Juli Br cell counter. Finally, the cells were seeded into 24 or 96-well plates and incubated in a CO2 incubator for 24 h at 37 °C. The number of cells was a sub-template of 1 × 104 or 2 × 103 cells per well. Test compounds at different concentrations (25–500 µg/mL) were added to the cells. The cultures were incubated for another 24 h. After this time, further tests were performed [60].
4.5.3. MTT Assay
The MTT assay was used to determine the effect of the tested extracts on the metabolic activity of the tested cell lines. The test results allow for the determination of the influence of tested compounds on the vitality or growth of cell cultures. Cells were incubated with the tested plant extracts for 24 h. After removing the medium with the test compounds, 1 mg/mL of MTT solution in MEM without phenol red and FBS was added to the plate (to each well), and the plates were incubated at 37 °C for 2 h. The medium was again removed, and the formazan crystals were dissolved in isopropanol. A MultiscanGo microplate reader (Thermo Scientific, Waltham, MA, USA) measured absorbance at 570 nm [61].
4.5.4. Cell viability
Cell viability was assessed after 24 h of incubation of the test extracts with cell cultures. After incubation in 24-well plates, cells were harvested into tubes as previously described using trypsin solution for detachment. The resulting cell suspension was centrifuged at 200× g for 5 min. The pellet was then resuspended in PBS. Samples were then transferred to chips and analyzed in a NucleoCounter® NC-200 (ChemoMetec A/S, Allerod, Denmark). Viability and quantity were measured using Via1-Cassette™ cassettes for cell sampling and staining. Acridine orange (AO) and 4′,6-diamidino-2-phenylindole (DAPI) fluorophores, immobilized in the cassette channels, were used for staining.
4.5.5. Measurement of Intracellular ROS Levels
Tested plant extracts were added to the cell cultures and incubated with the cells for 4 h. The cells were then washed and incubated with DCFH-DA (non-fluorescent probe) in the dark at 37 °C for 2 h in CO2. The non-fluorescent, non-polar probe DCFH-DA (2′7′-dichlorodihydrofluorescein diacetate) at a concentration of 25 μM was used as an oxidative stress marker to determine intracellular ROS levels. After this time, cells were washed twice with PBS, and PBS with 100 μL H2O2 was added (to a portion of the plates) for 30 min. During incubation, DCFH-DA inside the cells was hydrolyzed by esterases to a polar, non-fluorescent DCFH (2′7′-dichlorodihydrofluorescein) and then oxidized in the presence of ROS (reactive oxygen species) to fluorescent DCF (2′7′-dichlorofluorescein). DCF was measured using a Varioscan LUX microplate reader at λex = 485 nm and λem = 535 nm. Results were presented as E/E0, where E is the value of the test sample and E0 is the control value [62,63].
4.5.6. Statistical Analysis
All results in the tables are presented as mean ± SD (standard deviation) relative to the control (E/E0). E is the culture with the test compound, and E0 is the negative control without the compound. Statistical methods used were two-way ANOVA analysis of variance and Tukey’s post-hoc test. The point of significance was established * p < 0.05. Statistical analyses were performed with Statistica v.13 software.
5. Conclusions
The obtained results showed that the extracts of Solanum nigrum L. from its aerial parts possess antimicrobial properties that can be used as a natural antimicrobial agent for infectious diseases of humans, animals and plants. The extract from aerial parts had the most efficient bactericidal activity against plant pathogens of the genus Pectobacterium (MBC = 250 g/mL). The most efficient fungistatic effects of S. nigrum extracts were observed against the fungi A. alternata and Ch. globosum (50–56% inhibition). Both extracts show chemopreventive properties such as anticancer and antioxidant activities. The activity is due to the high content of isoquercetin, naringenin and its derivatives, rutin, demissine, solamargine, solanidine, solanine, solasodine, solasonine and tomatine; however, further analysis is needed to correlate the obtained results with the phytochemical composition of the organic extracts from the aerial parts of the nightshade.
Supplementary Materials
The following supporting information can be downloaded at: https://www.mdpi.com/article/10.3390/app12146845/s1, Chromatograms are given as Supplementary files.
Author Contributions
Conceptualization, E.G., T.G.; Methodology, E.G., J.Ł., T.G., M.R., E.P.; validation, T.G.; formal analysis, E.G., J.Ł., M.R., E.P., H.G., T.G.; investigation, E.G., J.Ł., M.R., E.P., H.G., T.G.; resouces: E.G., J.Ł., T.G.; data curation, E.G., T.G.; writing—original draft preparation, E.G., J.Ł., M.R., T.G., E.P., H.G.; writing—review and editing, E.G., J.Ł., T.G., B.W., A.K.; project administration, E.G. All authors have read and agreed to the published version of the manuscript.
Funding
The APC/BPC is financed/co-financed by Wroclaw University of Environmental and Life Sciences.
Institutional Review Board Statement
Not applicable.
Informed Consent Statement
Not applicable.
Data Availability Statement
Not applicable.
Conflicts of Interest
The authors declare no conflict of interest.
References
- Prestinaci, F.; Pezzotti, P.; Pantosti, A. Antimicrobial resistance: A global multifaceted phenomenon. Pathog. Glob. Health. 2015, 109, 309–318. [Google Scholar] [CrossRef] [PubMed]
- Maillard, J. Resistance of Bacteria to Biocides. Microbiol. Spectrum. 2018, 6, 19. [Google Scholar] [CrossRef] [PubMed]
- Partridge, S.R.; Kwong, S.M.; Firth, N.; Jensen, S.O. Mobile genetic elements associated with antimicrobial resistance. Clin. Microbiol. Rev. 2018, 31, e00088-17. [Google Scholar] [CrossRef] [PubMed]
- Khan, A.A.; Manzoor, K.N.; Sultan, A.; Saeed, M.; Rafique, M.; Noushad, S.; Talib, A.; Rentschler, S.; Deigner, H.-P. Pulling the Brakes on Fast and Furious Multiple Drug-Resistant (MDR) Bacteria. Int. J. Mol. Sci. 2021, 22, 859. [Google Scholar] [CrossRef]
- Betoni, J.E.; Mantovani, R.P.; Barbosa, L.N.; Di Stasi, L.C.; Fernandes Junior, A. Synergism between plant extract and antimicrobial drugs used on Staphylococcus aureus diseases. Mem. Inst. Oswaldo Cruz. 2006, 101, 387–390. [Google Scholar] [CrossRef]
- Barah, F. Non-Antibiotic Biocides: An Updated Review. Microbial Pathogens and Strategies for Combating Them: Science, Technology and Education; Méndez-Vilas, A., Ed.; Formatex Research Centre: Badajoz, Spain, 2013; Volume 1, pp. 598–607. [Google Scholar]
- Bakkali, F.; Averbeck, S.; Averbeck, D.; Idaomar, M. Biological effects of essential oils—A Review. Food Chem. Toxicol. 2008, 46, 446–475. [Google Scholar] [CrossRef]
- Silva, N.; Fernandes Júnior, A. Biological properties of medicinal plants: A review of their antimicrobial activity. J. Venom. Anim. Toxins Incl. Trop. Dis. 2010, 16, 402–413. [Google Scholar] [CrossRef]
- Szandruk-Bender, M.; Rutkowska, M.; Merwid-Ląd, A.; Wiatrak, B.; Szeląg, A.; Dzimira, S.; Sobieszczańska, B.; Krzystek-Korpacka, M.; Kucharska, A.Z.; Matuszewska, A.; et al. Cornelian Cherry Iri-doid-Polyphenolic Extract Improves Mucosal Epithelial Barrier Integrity in Rat Experimental Colitis and Exerts Antimicrobial and Antiadhesive Activities In Vitro. Oxid. Med. Cell. Longev. 2020, 2020, 7697851. [Google Scholar] [CrossRef]
- Sporn, M.B.; Liby, K.T. Chemoprevention of Cancer: Past, Present, and Future. In Natural Products for Cancer Chemoprevention; Pezzuto, J., Vang, O., Eds.; Springer: Cham, Switzerland, 2020. [Google Scholar] [CrossRef]
- Merwid-Ląd, A.; Ksiądzyna, D.; Hałoń, A.; Szkudlarek, D.; Trocha, M.; Szandruk-Bender, M.; Matuszewska, A.; Nowak, B.; Sozański, T.; Kuźniar, A.; et al. Morin-5’-Sulfonic Acid Sodium Salt (NaMSA) Attenuates Cyclophosphamide-Induced Histological Changes in Genitourinary Tract in Rats-Short Report. Pharmaceuticals 2021, 14, 192. [Google Scholar] [CrossRef]
- Kikuchi, H.; Yuan, B.; Hu, X.; Okazaki, M. Chemopreventive and anticancer activity of flavonoids and its possibility for clinical use by combining with conventional chemotherapeutic agents. Am. J. Cancer Res. 2019, 9, 1517–1535. [Google Scholar]
- Grosso, G.; Micek, A.; Godos, J.; Pajak, A.; Sciacca, S.; Galvano, F.; Giovannucci, E.L. Dietary flavonoid and lignan intake and mortality in prospective cohort studies: Systematic review and dose-response meta-analysis. Am. J. Epidemiol. 2017, 185, 1304–1316. [Google Scholar] [CrossRef]
- Godos, J.; Castellano, S.; Ray, S.; Grosso, G.; Galvano, F. Dietary polyphenol intake and depression: Results from the mediterranean healthy eating, lifestyle and aging (MEAL) study. Molecules 2018, 23, 999. [Google Scholar] [CrossRef]
- Sak, K. Intake of individual flavonoids and risk of carcinogenesis: Overview of epidemiological evidence. Nutr. Cancer 2017, 69, 1119–1150. [Google Scholar] [CrossRef]
- Imran, M.; Rauf, A.; Shah, Z.A.; Saeed, F.; Imran, A.; Arshad, M.U.; Ahmad, B.; Bawazeer, S.; Atif, M.; Peters, D.G.; et al. Chemopreventive and therapeutic effect of the dietary flavonoid kaempferol: A comprehensive review. Phytother. Res. 2019, 33, 263–275. [Google Scholar] [CrossRef]
- Zanoaga, O.; Braicu, C.; Jurj, A.; Rusu, A.; Buiga, R.; Berindan-Neagoe, I. Progress in Research on the Role of Flavonoids in Lung Cancer. Int. J. Mol. Sci. 2019, 20, 4291. [Google Scholar] [CrossRef]
- Yao, M.; Yuan, B.; Wang, X.; Sato, A.; Sakuma, K.; Kaneko, K.; Komuro, H.; Okazaki, A.; Hayashi, H.; Toyoda, H.; et al. Synergistic cytotoxic effects of arsenite and tetrandrine in human breast cancer cell line MCF-7. Int. J. Oncol. 2017, 51, 587–598. [Google Scholar] [CrossRef]
- Moga, M.A.; Dimienescu, O.G.; Arvatescu, C.A.; Mironescu, A.; Dracea, L.; Ples, L. The Role of Natural Polyphenols in the Prevention and Treatment of Cervical Cancer—An Overview. Molecules 2016, 21, 1055. [Google Scholar] [CrossRef]
- Górniak, I.; Bartoszewski, R.; Króliczewski, J. Comprehensive review of antimicrobial activities of plant flavonoids. Phytochem. Rev. 2019, 18, 241–272. [Google Scholar] [CrossRef]
- Djeussi, D.E.; Noumedem, J.A.; Seukep, J.A.; Fankam, A.G.; Voukeng, I.K.; Tankeo, S.B.; Nkuete, A.H.; Kuete, V. Antibacterial activities of selected edible plants extracts against multidrug-resistant Gram-negative bacteria. BMC Complement. Altern. Med. 2013, 13, 164. [Google Scholar] [CrossRef]
- Subramani, R.; Narayanasamy, M.; Feussner, K.D. Plant-derived antimicrobials to fight against multi-drug-resistant human pathogens. Biotech 2017, 7, 172. [Google Scholar] [CrossRef]
- Edmonds, J.M.; Chweya, J.A. Black Nightshades—Solanum nigrum L. and Related Species; International Plant Genetics Research Institute: Rome, Italy, 1997; ISBN 10-9290433213. [Google Scholar]
- Mohy-ud-dint, A.; Khan, Z.; Ahmad, M.; Kashmiri, M.A. Chemotaxonomic value of alkaloids in Solanum nigrum complex. Pak. J. Bot. 2010, 42, 653–660. [Google Scholar]
- Dhellot, J.R.; Matouba, E.; Maloumbi, M.G.; Nzikou, J.M.; Dzondo, M.G.; Nzikou, J.M.; Dzondo, M.G.; Linder, M.; Parmentier, M.; Desobry, S. Extraction and nutritional properties of Solanum nigrum L. seed oil. Afr. J. Biotechnol. 2006, 5, 987–991. [Google Scholar]
- Al-Qirim, T.; Zaidi, S.M.; Shahwan, M.; Shattat, G.; Banu, N. Effect of Solanum nigrum on immobilization stress induced antioxidant defense changes in rat. Res. Biol. Sci. 2008, 3, 1426–1429. [Google Scholar]
- Dukes, J.A. CRC Handbook of Medicinal Herbs, 1st ed.; CRC Press, Inc.: Boca Raton, FL, USA, 1985. [Google Scholar]
- Raju, R.; Rao, C.V. Diosgenin, a Steroid Saponin Constituent of Yams and Fenugreek: Emerging Evidence for Applications in Medicine. Bioact. Compd. Phytomedicine 2012, 125, 143. [Google Scholar] [CrossRef]
- Gabrani, R.; Jain, R.; Sharma, A.; Sarethy, I.P.; Dang, S.; Gupta, S. Antiproliferative Effect of Solanum nigrum on Human Leukemic Cell Lines. Indian J. Pharm. Sci. 2012, 74, 451–453. [Google Scholar] [CrossRef]
- Tai, C.J.; Wang, C.K.; Chang, Y.J.; Lin, C.S.; Tai, C.J. Aqueous Extract of Solanum nigrum Leaf Activates Autophagic Cell Death and Enhances Docetaxel-Induced Cytotoxicity in Human Endometrial Carcinoma Cells. Evid.-Based Complem. Altern. Med. 2012, 10, 859185. [Google Scholar] [CrossRef]
- Campisi, A.; Acquaviva, R.; Raciti, G.; Duro, A.; Rizzo, M.; Santagati, N.A. Antioxidant Activities of Solanum nigrum L. Leaf Extracts Determined in In Vitro Cellular Models. Foods 2019, 8, 63. [Google Scholar] [CrossRef]
- Nawaz, A.; Jamal, A.; Arif, A.; Parveen, Z. In vitro cytotoxic potential of Solanum nigrum against human cancer cell lines. Saudi. J. Biol. Sci. 2021, 28, 4786–4792. [Google Scholar] [CrossRef]
- Aryal, S.; Baniya, M.K.; Danekhu, K.; Kunwar, P.; Gurung, R.; Koirala, N. Total phenolic content, flavonoid content and antioxidant potential of wild vegetables from Western Nepal. Plants 2019, 8, 96. [Google Scholar] [CrossRef]
- Kumar, S.; Sharma, U.K.; Sharma, A.K.; Pandey, A.K. Protective efficacy of Solanum xanthocarpum root extracts against free radical damage: Phytochemical analysis and antioxidant effect. Cell. Mol. Biol. 2012, 58, 174–181. [Google Scholar]
- Wu, S.B.; Meyer, R.S.; Whitaker, B.D.; Litt, A.; Kennelly, E.J. A new liquid chromatography-mass spectrometry-based strategy to integrate chemistry, morphology, and evolution of eggplant (Solanum) species. J. Chromatogr. A 2013, 1314, 154–172. [Google Scholar] [CrossRef] [PubMed]
- Atanu, F.O.; Ebiloma, U.G.; Ajayi, E.I. A review of the pharmacological aspects of Solanum nigrum Linn. Biotechnol. Mol. Biol. Rev. 2011, 6, 1–7. [Google Scholar]
- Chauhan, A.; Ruby, K.M.; Shori, A.; Dwivedi, J. Solanum nigrum with dynamic therapeutic role: A review. Int. J. Pharm. Sci. Rev. Res. 2012, 15, 65–71. [Google Scholar]
- Patel, K.; Singh, R.B.; Patel, D.K. Medicinal significance, pharmacological activities, and analytical aspects of solasodine: A concise report of current scientific literature. J. Acute Dis. 2013, 2, 92–98. [Google Scholar] [CrossRef]
- Silva-Beltrán, N.P.; Ruiz-Cruz, S.; Cira-Chávez, L.A.; Estrada-Alvarado, M.I.; Ornelas-paz, J.D.J.; López-mata, M.A.; Del-toro-Sánchez, C.L.; Ayala-Zavala, J.F.; Márquez-ríos, E. Tomatidine Contents and Antioxidant and Antimicrobial Activities of Extracts of Tomato Plant. Int. J. Anal. Chem. 2015, 2015, 1–10. [Google Scholar] [CrossRef]
- Hameed, A.; Ijaz, S.; Shair Mohammad, I.; Sher Muhammad, K.; Akhtar, N.; Shoaib Khan, H.M. Aglycone solanidine and solasodine derivatives: A natural approach towards cancer. Biomed. Pharmacother 2017, 94, 446–457. [Google Scholar] [CrossRef]
- Kozłowska, J.; Grela, E.; Baczyńska, D.; Grabowiecka, A.; Anioł, M. Novel O-alkyl Derivatives of Naringenin and Their Oximes with Antimicrobial and Anticancer Activity. Molecules 2019, 24, 679. [Google Scholar] [CrossRef]
- Sing, M.; Govindarajan, R.; Rawat, A.K.S. Antimicrobial Flavonoid Rutin from Pteris Vittata L. Against Pathogenic Gastrointestinal Microflora Antimicrobial Flavonoid Rutin from Pteris vittata L. against Pathogenic Gastrointestinal Microflora. Am. Fern. J. 2021, 98, 98–103. [Google Scholar] [CrossRef]
- Gadoh Abbas, H.; Abdul-Imam Almazini, M.; Abdul-Amer, A. Antibacterial Activity of the Solasodine of Solanum Nigrum Against Bacterial Isolates From the Wounds. Basrah J. Vet. Res. 2009, 8, 137–147. [Google Scholar] [CrossRef][Green Version]
- Chowdhury, N.; Anupam, G.; Chandra, G. Mosquito larvicidal activities of Solanum villosum berry extract against the dengue vector Stegomyia aegypti. BMC Complemen. Alternat. Med. 2008, 8, 1–8. [Google Scholar] [CrossRef]
- Othman, N.A.M.R. Solanum nigrum roots as an antibacterial agent. Int. J. ChemTech Res. 2017, 10, 436–441. [Google Scholar]
- Parameswari, K.; Sudheer, A.; Kishori, B. In Vitro Antibacterial Activity in the extracts of solanumnigrum. Indian Streams Res. J. 2012, 2, 2230–7850. [Google Scholar] [CrossRef]
- Rajathi, D.; Modilal, M.; Anandan, R.; Sindhu, R.; Logeshwari, M.N. Screening of Solanum Nigrum for Its Phytochemical and Antimicrobial Activity Against Respiratory Tract Pathogens. Inter. J. Pure Appl. Zool. 2015, 3, 210–215. [Google Scholar]
- Gbadamosi, I.T.; Afolayan, A.J. In vitro anti-radical activities of extracts of Solanum nigrum (L.) from South Africa. J. Appl. Biosci. 2016, 98, 9240–9251. [Google Scholar] [CrossRef]
- Shahiladevi, L.; Jegadeesa, M. Antimicrobial Activity of Black Fruit Variant of Solanum nigrum L. Int. J. Curr. Microbiol. App. Sci. 2017, 6, 2706–2713. [Google Scholar] [CrossRef]
- Moglad Ehssan, H.O.; Abdalla, O.M.; Koko, W.S.; Saadabi, A.M. In vitro Anticancer Activity and Cytotoxicity of Solanum nigrum on Cancers and Normal Cell Lines. Int. J. Cancer Res. 2014, 10, 74–80. [Google Scholar]
- Javed, T.; Ashfaq, U.A.; Riaz, S.; Rehman, S.; Riazuddin, S. In vitro antiviral activity of Solanum nigrum against hepatitis C virus. Virol. J. 2011, 8, 26. [Google Scholar] [CrossRef]
- Kang, H.; Jeong, H.D.; Choi, H.Y. The chloroform fraction of Solanum nigrum suppresses nitric oxide and tumor necrosis factor α in LPS stimulated mouse peritoneal macrophages through inhibition of p38, JNK and ERK1/2. Am. J. Chin. Med. 2011, 39, 1261–1273. [Google Scholar] [CrossRef]
- Lin, H.M.; Tseng, H.C.; Wang, C.J.; Lin, J.J.; Lo, C.W.; Chou, F.P. Hepatoprotective effects of Solanum nigrum Linn. extract against CCl4 induced oxidative damage in rats. Chem. Biol. Interact. 2008, 171, 283–293. [Google Scholar] [CrossRef]
- Hsieh, C.C.; Fang, H.L.; Lina, W.C. Inhibitory effect of Solanum nigrum on thioacetamide induced liver fibrosis in mice. J. Ethnopharmacol. 2008, 119, 117–221. [Google Scholar] [CrossRef]
- Karthi, N.; Kalaiyarasu, T.; Kandakumar, S.; Mariyappan, P.; Manju, V. Pelargonidin induces apoptosis and cell cycle arrest via a mitochondria mediated intrinsic apoptotic pathway in HT29 cells. RSC Adv. 2016, 51, 45064–45076. [Google Scholar] [CrossRef]
- Matuschek, E.; Brown, D.F.J.; Kahlmeter, G.; Canton, R. Development of the EUCAST disk diffusion antimicrobial susceptibility testing method and its implementation in routine microbiology laboratories. Clin. Microbiol. Infect. 2014, 20, 255–266. [Google Scholar] [CrossRef]
- CLSI. Performance Standards for Antimicrobial Susceptibility Testing, 27th ed.; CLSI Supplement M100; Clinical and Laboratory Standards Institute: Wayne, PA, USA, 2017. [Google Scholar]
- Gleń, K.; Boligłowa, E. Evaluation the fungistatic activity of plant extracts in vitro tests. J. Res. Appl. Agricult. Engin. 2012, 57, 104–109. [Google Scholar]
- Kowalik, R.; Krechniak, E. Materials for the Research Methodology of Biological Evaluation of Plant Protection Products; IOR: Poznań, Poland, 1961; pp. 35–48. [Google Scholar]
- Arendt-Pindel, A.; Marszałek-Harych, A.; Gębarowska, E.; Gębarowski, T.; Jędrzkiewicz, D.; Pląskowska, E.; Zalewski, D.; Gulia, N.; Szaferta, S.; Ejfler, J. Design and functionalization of bioactive benzoxazines. An unexpected ortho-substitution effect. New J. Chem. 2019, 43, 12042–12053. [Google Scholar] [CrossRef]
- Piasny, J.; Wiatrak, B.; Dobosz, A.; Tylińska, B.; Gębarowski, T. Antitumor Activity of New Olivacine Derivatives. Molecules 2020, 25, 2512. [Google Scholar] [CrossRef]
- Glomb, T.; Wiatrak, B.; Gębczak, K.; Gębarowski, T.; Bodetko, D.; Czyżnikowska, Ż.; Świątek, P. New 1,3,4-Oxadiazole Derivatives of Pyridothiazine-1,1-Dioxide with Anti-Inflammatory Activity. Int. J. Mol. Sci. 2020, 21, 9122. [Google Scholar] [CrossRef] [PubMed]
- Grajzer, M.; Wiatrak, B.; Gębarowski, T.; Matkowski, A.; Grajeta, H.; Rój, E.; Kulma, A.; Prescha, A. Chemistry, oxidative stability and bioactivity of oil extracted from Rosa rugosa (Thunb.) seeds by supercritical carbon dioxide. Food Chem. 2021, 15, 335. [Google Scholar] [CrossRef] [PubMed]
Publisher’s Note: MDPI stays neutral with regard to jurisdictional claims in published maps and institutional affiliations. |
© 2022 by the authors. Licensee MDPI, Basel, Switzerland. This article is an open access article distributed under the terms and conditions of the Creative Commons Attribution (CC BY) license (https://creativecommons.org/licenses/by/4.0/).